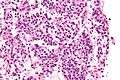

Typical pulmonary carcinoid tumour
| Typical pulmonary carcinoid tumour | |
|---|---|
 | |
| Micrograph of a typical pulmonary carcinoid tumour. | |
| Classification and external resources |
Typical pulmonary carcinoid tumour is a subtype of pulmonary carcinoid tumour. It is an uncommon low-grade malignant lung mass that is most often in the central airways of the lung.[1] It is also known as typical lung carcinoid tumour, lung carcinoid, and typical lung carcinoid.
Symptoms
Lung carcinoids typically present with a cough or hemoptysis.[2] Findings may closely mimic malignant tumours of the lung, i.e. lung cancer.
Diagnosis
.jpg)
The definitive diagnosis is rendered by a microscopic examination, after excision. Typical carcinoids have cells with stippled chromatin and a moderate quantity of cytoplasm. They typically have few mitoses and lack necrosis. By definition, they are greater than 4 mm in largest dimension; smaller lesions are referred to as pulmonary carcinoid tumourlets.
The differential diagnosis of typical pulmonary carcinoid tumour includes: atypical pulmonary carcinoid tumour, pulmonary carcinoid tumourlet and lung adenocarcinoma.
Treatment
Typical carcinoids are usually treated with surgical excision.
See also
Additional images
Very high magnification
Very high magnification
References
- ↑ Meisinger, QC.; Klein, JS.; Butnor, KJ.; Gentchos, G.; Leavitt, BJ. (Nov 2011). "CT features of peripheral pulmonary carcinoid tumors.". AJR Am J Roentgenol. 197 (5): 1073–80. doi:10.2214/AJR.10.5954. PMID 22021498.
- ↑ Gungor, S.; Damadoglu, E.; Aybatli, A.; Yilmaz, A.; Kir, A.; Akkaya, E. (Jul 2006). "Typical pulmonary carcinoid tumors: presentation and outcome of 24 cases.". Med Sci Monit. 12 (7): CR315–8. PMID 16810137.